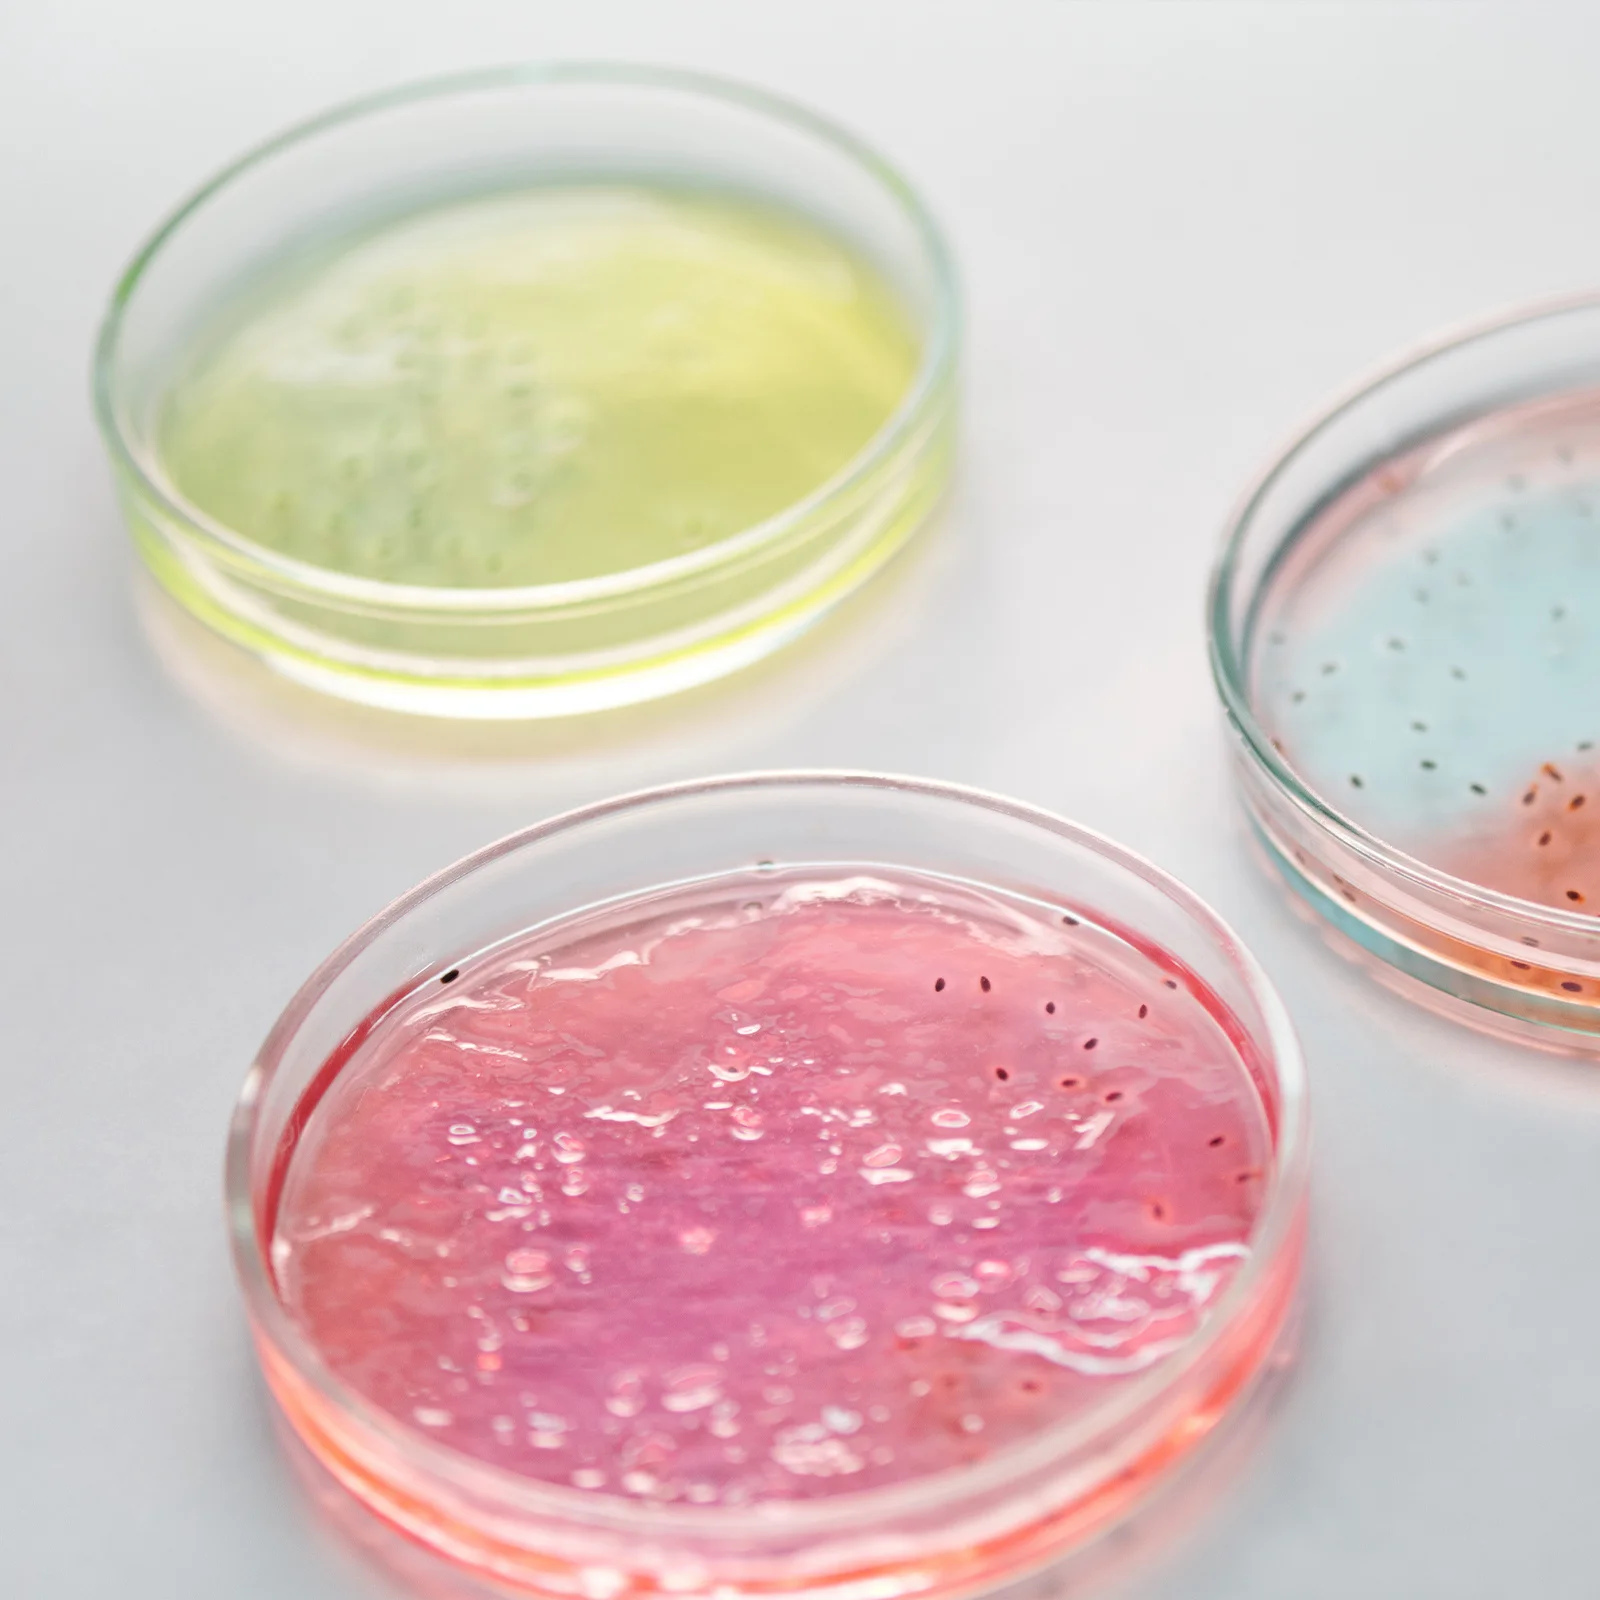
Laboratory Glass Petri Dish Heat Resistant Flat Bottom Culture Plate Durable Lightweight Agar Plates Science Supplies

KARACA Набор металлических чайников миди с индукционным основанием
График изменения цены & курс обмена валют
Пользователи также просматривали

1,716.54 руб.
Fit NSK KAVO SIRONA WH COXO Dental Turbine Cartridge Air Rotor For High Speed Handpiece Dentistry Handpiece Products
aliexpress.com
407.20 руб.
50 Pcs Small Envelopes Colored Paper Holder Card Container Letter Shell Solid Colorful Envelope Photo Supply Paper Envelopes
aliexpress.com
276.84 руб.
1/2PCS Laser Taillight 5 LED Waterproof Cycling Light Safety Warning Light Tail Light Фонарь
aliexpress.com
2,288.72 руб.
Женский элегантный вязаный свитер из двух предметов Кардиган с длинным рукавом и эластичное облегающее платье-карандаш с V-образным вырезом и нескользящей юбкой на осень и зиму
aliexpress.ru
955.24 руб.
Мужская футболка I a Mom I имеет право быть ленивым и бралом, когда я обнаружу время, чтобы быть женским, Мужская футболка
aliexpress.ru
629.32 руб.
Светодиодная шлейка K5DC для собак, удобный Регулируемый жилет на батарейках, для ночных прогулок
aliexpress.ru
338.80 руб.
2022 женское нижнее белье, ультратонкие трусики, дышащие трусики Inimate, кружевные подштанники, женское нижнее белье, однотонные сексуальные тр...
aliexpress.ru
835.33 руб.
Форма для Смола B36D гном, форма для украшения Дня Святого Валентина, форма для изготовления свечей, форма для отливки эпоксидной смолы Санта-Клауса
aliexpress.ru
1,814.72 руб.
Плата контроллера экрана ноутбука, подходит для HSD101PFW2 HSD101PFW4 VGA DVI 1024*600 10,1 "HDMI-совместимый LVDS 40-контактный Комплект «сделай сам»
aliexpress.ru
92,546.58 руб.
DC 48V to AC110V/ 220V/230V/240V Pure Sine Wave 8000W солнечный инвертор с пультом дистанционного управления
aliexpress.ru
313.05 руб.
Портативная Водонепроницаемая прозрачная косметичка, Модный Полосатый органайзер для косметики на молнии, Женская дорожная сумка для туал...
aliexpress.ru
255.91 руб.
MERCURY GOOSPERY Sky Series for Samsung Galaxy S22+ 5G Anti-fall Anti-scratch Slide Design Card Holder PC + TPU Cell Phone Case - Gold, Galaxy S22+ 5G
tvc-mall.com
1,442.92 руб.
Щетка для унитаза, набор губки с пластиковой ручкой, держатель для унитаза, чистящие инструменты для ванной комнаты, инструменты для мытья п...
aliexpress.ru
1,823.57 руб.
Новая мужская одежда жареные снежинки Тяжелая промышленная потертая с коротким рукавом окантовка двойная Ретро Уличная мода
aliexpress.ru
1,142.75 руб.
Ветровка приталенная уличная дышащая куртка с капюшоном «очень странные дела» водонепроницаемая верхняя одежда модная Толстовка дышащая ...
aliexpress.ru
489.29 руб.
Женский холщовый рюкзак в стиле Харадзюку, милые школьные ранцы карамельных цветов для студенток, многофункциональный дорожный ранец
aliexpress.ru
3,631.85 руб.
Женское ожерелье из серебра 100% пробы, с подвеской в виде четырехлистного цветка
aliexpress.ru
2,184.10 руб.
moon earth anime galaxy animal print 3d summer 3d print shirts kawaii aesthetic plus size men clothing
dhgate.com
147.27 руб.
New USB Blueteeth V2.1+EDR Stereo Audio Music Wireless Receiver Adapter For Car Home Speaker USB Blueteeth Music Receiver #PY10
aliexpress.com
1,045.37 руб.
Henglong original 1:16 battle remote control tank infrared receiver universal accessories 6.0 infrared receiver
aliexpress.com
49.09 руб.
Desk Drawer Lock Cabinet Latch Silver Key Chassis Door Lock Hinge Replacement Tool Box Locks Hardware Security Storage
aliexpress.ru
1,972.45 руб.
Сельскохозяйственный рюкзак, интеллектуальный перезаряжаемый лейка для пестицидов, электрический распылитель (за исключением жидкости)
aliexpress.ru
2,526.92 руб.
Подходит для барабанных стиральных машин Midea Little Swan, аксессуары, оригинальный кронштейн для штатива, уплотнительное кольцо подшипника водяного уплотнения
aliexpress.ru
118.30 руб.
Heavy Duty Hammock Chair Spring 6.7Mm Galvanized Steel For Hanging Chairs Punching Bags Plants Outdoor Furniture Hammock
aliexpress.ru
186.70 руб.
Laboratory Glass Petri Dish Heat Resistant Flat Bottom Culture Plate Durable Lightweight Agar Plates Science Supplies
aliexpress.ru
67,031.89 руб.
pgMedieval wabi-sabi wind retro round solid wood coffee table living room creativity, log carving coffee table
aliexpress.ru


/chereviki-turistichni-mustang-1408-603-301-kastanie.jpg)



